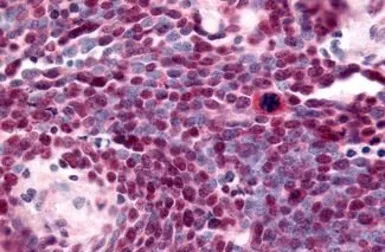

NR2E1 antibody
Cat. No. GTX78013
Cat. No. GTX78013
-
HostRabbit
-
ClonalityPolyclonal
-
IsotypeIgG
-
ApplicationsIHC-P
-
ReactivityHuman, Rabbit, Bovine, Dog, Pig, Monkey, Bat, Horse